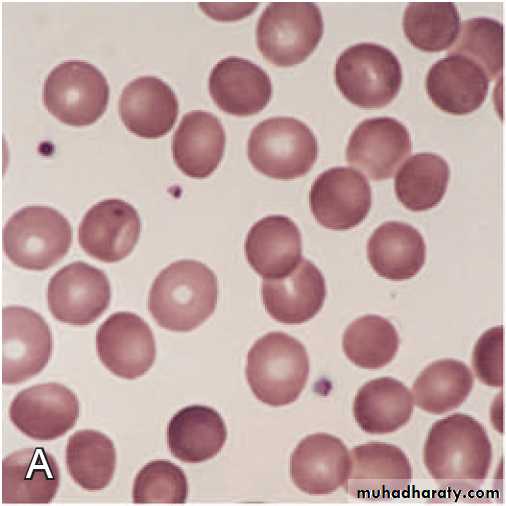
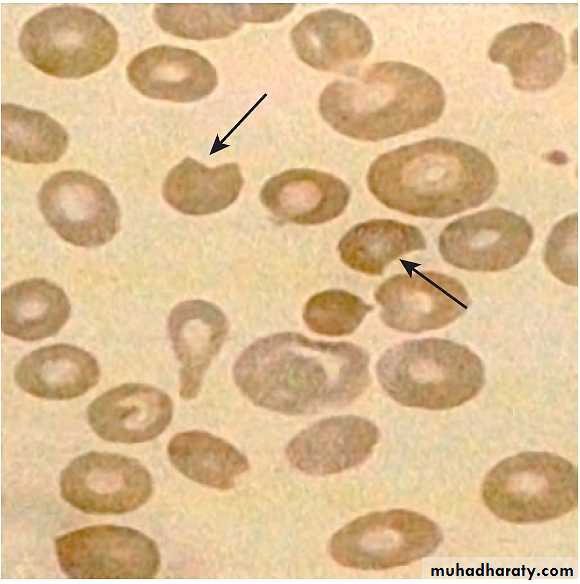

HEMOLYTIC ANAEMIAS
BYDR. ATHL HUMO
2016-2017
HEMATOLOGY
- 2 -
HEMOLYTIC ANAEMIA
Hemolysis is defined as the premature destruction of RBCs (a shortened RBC life span). Anemia results when the rate of destruction exceeds the capacity of the marrow to produce RBCs.The lifespan of a normal red cell is 120 days. In haemolysis, red cell survival may be reduced to a few days but bone marrow production can increase about eightfold, so haemolysis only leads to anaemia when the bone marrow is no longer able to compensate for the premature destruction of red cells.
Heightened RBC production, reflected in an increased percentage of reticulocytes in the blood. Thus, hemolysis should be suspected as a cause of anemia if an elevated reticulocyte count is present.
The reticulocyte count may also be elevated
as a response to acute blood loss.
for a short period after replacement therapy for iron, vitamin B12, or folate deficiency.
The reticulocyte percentage can be corrected to measure the magnitude of marrow production in response to hemolysis as follows:
Red cell Destruction & Catabolism of Hb
CLASSIFICATION
• CELLULAR DEFECTS (Intrinsic Abnormalities)• EXTRACELLULAR DEFECTS (Extrinsic Abnormalities)
Antibodies:Autoimmune HA
Mechanical factors:
DIC, TTP, HUS
Prosthetic heart valve
Burns, thermal injury
Hypersplenism
Plasma factors:
Liver disease
Wilson disease
Infections
DIAGNOSIS
• Anaemia(↓ Hb).
• Raised reticulocyte count (polychromasia on blood film).
• Raised unconjucated bilirubin.
• Raised LDH
• Decreased haptoglobins
• Positive direct antiglobulin test (only if an immune cause as this test identifies antibody-coated red blood cells)
• Increased erythropoiesis in the bone marrow.
• Abnormal appearance of the red cells on a blood film (e.g. spherocytes, sickle shaped)
• Reticuloendothelial hyperplasia - hepatomegaly and splenomegaly
HS is transmitted as an autosomal dominant or, less commonly, as an autosomal recessive disorder.
Molecular defect in protein spectrin, ankyrin or other proteins that are provide stability of RBC membrane shape. This results in the red cell losing part of its membrane, this reduction in its surface-to-volume ratio causes the cells to become spheroidal, making them less deformable than normal red blood cells and leads to their destruction in the microvasculature of the spleen.
HEREDITARY SPHEROCYTOSIS
Pathophysiology of Hereditary SpherocytosisDIAGNOSIS
Diagnosis of HS depend on:• Family history.
• Clinical features.
• Laboratory study.
CLINICAL MANIFESTATIONS
The clinical spectrum varies widely.Affected patients may be asymptomatic, without anemia and with minimal hemolysis.
Or they may have severe hemolytic anemia associated with growth failure, splenomegaly, chronic transfusions need splenectomy.
• Jaundice: usually develops during childhood but may cause severe hemolytic jaundice in the first few days of life.
• Anaemia .
• Mild to moderate splenomegaly - depends on the rate of hemolysis.
• Aplastic crisis - uncommon, associated with parvovirus B19 infection
• Gallstones - due to increased bilirubin excretion.
• Rare complications associated with HS include splenic sequestration crisis, gout, cardiomyopathy, leg ulcers, and spinocerebellar degeneration.
LABORATORY STUDY
The hemoglobin level usually is 6-10 g/dL, but it can be normal.MCHC ↑(36-38 g/dl)
MCV NR.
Retics ↑(mean 10%).
Blood film:
Small spherocyte, hyperchromic with central pallor is less conspicuous.
Polychromasia.
↓ haptoglobin.
US may show gallstone.
If the diagnosis is less certain, the recommended tests that have a high predictive value for HS are the flow cytometric EMA (eosin-5- maleimide) binding test and the cryohemolysis test.
Osmotic fragility test can detect the presence of spherocytes in the blood; however, it is not specific to HS and may be abnormal in other hemolytic anemias.
Blood Film of Hereditary Spherocytosis
TREATMENT
Folic acid supplementation.Blood transfusion for aplastic crises.
Splenectomy is recommended for:
patients with severe HS.
patients with moderate HS and frequent hypoplastic or aplastic crises, poor growth, or cardiomegaly.
• When splenectomy is indicated, it should be performed after the age of 6 yr, if possible, to avoid the heightened risk of postsplenectomy sepsis in younger children.
• Vaccines for encapsulated organisms, such as pneumococcus, meningococcus, and H. influenzae type b, should be administered at least 14 days before splenectomy, and prophylactic oral penicillin prescribed indefinitely.
Cholecystectomy for gallstones.
Glucose-6-Phosphate Dehydrogenase Deficiency (G6PD)
G6PD deficiency, the most frequent disease involving enzymes of the hexose monophosphate pathway. and is essential for preventing oxidative damage to red cells. Red cells lacking G6PD are susceptible to oxidant-induced haemolysis.G6PD deficency is X-linked inheritance, therefore the symptoms occur more frequently in males than in females. Rarely, the symptoms appear in heterozygous females because the random inactivation of the normal X chromosome (Lyon hypothesis).
The global distribution of this disorder parallels that of malaria, representing an example of “balanced polymorphism,” in which there is an evolutionary advantage of resistance to falciparum malaria in heterozygous females that outweighs the small negative effect of affected hemizygous males.
Many different mutations of the gene have been described, leading to different clinical features in different populations.
Young red blood cells may have normal enzyme activity whilst older cells are deficient.
Clinical Manifestations
Neonatal jaundice: onset is usually in the first 3 days of life, even kernicterus may occur.Acute haemolysis: most individuals with G6PD deficiency are asymptomatic, with no clinical manifestations of illness unless triggered by infection or a substance with oxidant properties, The degree of hemolysis varies with the inciting agent, amount ingested, and severity of the enzyme deficiency. The symptoms of intravascular haemolysis appear 24-48 h after exposure to triggering factors:
• Anaemia , may be severe lead to shock & acidosis.
• Jaundice
• Dark urine, as it contains haemoglobin as well as urobilinogen.
• Malaise.
Agents Precipitating Hemolysis in G6PD Deficiency
FOOD: fava beans known as favism. Fava beans contain divicine, convicine & isouramil which ultimately lead to production of hydrogen peroxide and other reactive oxygen products.MEDICATIONS:
Antibacterials: sulfonamides, trimethoprim-sulfamethoxazole, nalidixic acid, chloramphenicol, nitrofurantoin.
Antimalarials: primaquine, chloroquine, quinacrine
Others: vitamin K, aspirin
CHEMICALS:
Benzene,
Naphthalene (moth balls)
ILLNESS:
Diabetic acidosis
Hepatitis
Sepsis
Laboratory Findings
• Fall in hemoglobin and hematocrit.
• Retics ↑
• Bilirubin ↑
• Haptoglobin ↓.
• hemoglobinuria.
• Bile pigment in the urine.
• Blood film: The RBC morphology during episodes of acute hemolysis is striking, appearing to have “bites” taken out of them (cookie cells). These are areas of absent hemoglobin that are produced by phagocytosis of Heinz bodies by splenic macrophages. When a patient with G6PD is exposed to significant oxidant stress, hemoglobin is oxidized, forming precipitates of hemoglobin called (Heinz bodies)
• Confirmation of diagnosis: by measuring G6PD activity in RBCs. During a haemolytic crisis, G6PD levels may be misleadingly elevated due to the higher enzyme concentration in reticulocytes, which are produced in increased numbers in response to the destruction of mature red cells. A repeat assay after few weeks is then required in the steady state to confirm the diagnosis.
Morphologic erythrocyte changes (anisopoikilocytosis,bite cells) during acute hemolysis in a G6PD-deficient patient. Arrows show bite cells
Treatment and Prevention
The treatment of G6PD deficiency is supportive.Transfusions are indicated when significant cardiovascular compromise is present.
Maintaining hydration and urine alkalization protects the kidneys against damage from precipitated free hemoglobin.
Prevention of hemolysis is by:
Avoidance of known oxidants.
Serious infection also is a potential precipitant of hemolysis in G6PD-deficient young children.
Sickle Cell Disease
Sickle cell disease is the collective name given to haemoglobinopathies in which HbS is inherited.Normal RBC
Sickle RBCPATHOPHYSIOLOGY
HbS forms as a result of a point mutation in codon 6 of the β-globin gene which causes a change in the amino acid encoded from glutamine to valine.In HbSS, the haemoglobin molecule becomes deformed (insoluble) in the deoxygenated state. HbS polymerises within red blood cells forming rigid tubular spiral bodies which deform the red cells into a sickle shape.
Irreversibly sickled red cells have a reduced lifespan and may be trapped in the microcirculation, resulting in thrombosis and therefore ischaemia in an organ or bone. This is exacerbated by hypoxia, acidosis, fever, hypothermia, and dehydration.
Sickle cell disease refers to not only patients with sickle cell anemia, but also to compound heterozygotes where one β-globin allele includes the sickle cell mutation and the second β-globin allele includes a gene mutation other than the sickle cell mutation, such as HbC & β-thalassemia.
In sickle cell anemia, HbS is commonly as high as 90% of the total hemoglobin; whereas as in sickle cell disease, HbS is >50% of all hemoglobin.
There are four main forms of SCD:
1-Sickle cell anaemia (HbSS) - patients are homozygous for HbS, i.e. virtually all their Hb is HbS; they have no HbA because they have no normal β-globin genes.2-SC disease (HbSC) - affected children inherit HbS from one parent and HbC from the other parent (HbC is formed as a result of a different point mutation in β-globin), so they also have no HbA because they have no normal β-globin genes.
3-Sickle β-thalassaemia - affected children inherit HbS from one parent and β-thalassaemia trait from the other. They have no normal β-globin genes and most patients can make no HbA and therefore have similar symptoms to those with sickle cell anaemia.
4-Sickle trait - inheritance of HbS from one parent and a normal β-globin gene from the other parent, so approximately 40% of the haemoglobin is HbS. They do not have sickle cell disease but are carriers of HbS, so can transmit HbS to their offspring. They are asymptomatic and are only identified as a result of blood tests. Rarely causes problems except under conditions of low oxygen tension.
CLINICAL MANIFESTATIONS
XR of an infant with SCA and acute dactylitis.
• The bones appear normal at the onset of the episode.• Destructive changes and periosteal reaction are evident 2 wk later.
Dactylitis in SCD
Blood Film in SCD
Target cell
Sickle cellMANAGEMENT
Prophylactic Penicillin: children with sickle cell anemia should receive prophylactic oral penicillin until at least 5 yr of age to prevent pneumococcus infection. An alternative for children who are allergic to penicillin is erythromycin.Immunizations: routine childhood immunizations, especially against pneumococcus & Haemophilus influenzae type b, as well as the annual administration of influenza vaccine, are highly recommended.
Folic acid: oral once daily .
Minimized vaso-occlusive crises, by avoiding exposure to cold, dehydration, excessive exercise, undue stress or hypoxia.
Treatment of acute painful crises should be with oral or intravenous analgesia according to need (may require opiates) and good hydration (oral or intravenous as required); infection should be treated with antibiotics; oxygen should be given if the oxygen saturation is reduced.
RBC transfusions or exchange transfusion is indicated for acute chest syndrome, stroke and priapism.
Treatment of chronic problems, children who have recurrent hospital admissions for painful vaso-occlusive crises or acute chest syndrome may benefit from hydroxyurea, a drug which increases their HbF production and helps protect against further crises.
BM transplantation, this is the only cure for sickle cell disease.
THALASSEMIA SYNDROME
• Thalassemia is hereditary hemolytic anemia characterized by decreased or absent synthesis of one or more globin subunits of the hemoglobin molecule.α-Thalassemia results from reduced synthesis of α-globin chains.
β-thalassemia results from reduced synthesis of β-globin chains.
PATHOPHYSIOLOGY
An imbalance in globin chain production is a hazard to the RBC, because it results in precipitation of excess unpaired globin chains within the red cell membrane, leading to:Ineffective erythropoiesis, cell death within the bone marrow.
Hemolytic anaemia, premature removal of circulating red cells by the spleen.
α-THALASSEMIA
• α-Thalassemias are usually the result of α gene deletion.• α-Thalassemia variants are found most often in populations of African or East Asian ancestry.
• Normally there are four α-globin genes; clinical manifestations of α-thalassemia variants reflect the number of genes affected.
• An α0 -mutation indicates no α-chains produced from that gene. An α+ mutation produces a decreased amount of α-globin chain.
β- THALASSEMIA
• The clinical phenotype of β-thalassemia is related to the degree of globin chain imbalance.• Normally there are two β-globin genes; clinical manifestations of β-thalassemia variants reflect the number of genes affected.
• Heterozygous β-thalassemia(β-thalassemia minor).
• Homozygous β-thalassemia (β-thalassemia major ‘Cooley anemia’ and intermedia).
Thomas B. Cooley: American pediatrician/ 1927
β- THALASSEMIA PATHOLOGY
Heterozygous β-thalassemia (β-thalassemia minor, trait)Clinical Features:
• Mild anemia (Hb about 10 gm/dl)
• Normal growth and development.
• Blood film: Hypochromia, microcytosis, and anisocytosis.
• Hemoglobin electrophoresis shows elevation of the Hb A2 level and, sometimes, elevation of the Hb F level.
• RBC count is elevated.
Therapy: No treatment is necessary.
It is important, however, that thalassemia minor is distinguished from iron deficiency to prevent inappropriate therapy with iron.Folic acid may be given.
Genetic counseling is also important.
Homozygous β-thalassemia
• Homozygous β-thalassemia (β-thalassemia major’ Cooley anemia’ and intermedia).
• Its autosomal recessive inheritance of mutation in B globin chain genes.
• Defect: Molecular defects range from complete absence of β-globin synthesis (genotype β0/β0) to partial reduction in the gene product from the affected locus (genotype β+/β+).
• Clinical Features: begin in the middle of the first year of life.
• The infant manifests a progressively severe hemolytic anemia and jaundice.• Marked HSM.
• FTT.
• The BM hyperplasia produces characteristic features such as tower skull, frontal bossing, maxillary hypertrophy with prominent cheekbones, and overbite.
• Hemochromatosis: Even in the untransfused state, iron overload develops in thalassemic patients because of hyper absorption of dietary iron. The iron load becomes even greater with chronic transfusion therapy. When the bone marrow storage capacity for iron is exceeded, iron accumulates in parenchymal organs such as the liver, heart, pancreas, gonads, and skin, producing the complications of hemochromatosis. Many patients develop congestive heart failure, hypogonadism, DM, hypothyroidism, liver cirrhosis and short stature.
β-Thalassemia
Investigations:
• CBC & smear: hypochromic microcytic anemia, with nucleated RBC & reticulocytopenia.• Elevated unconjucated bilirubin.
• Hemoglobin electrophoresis, Hb A is either markedly decreased or totally absent. Of the total hemoglobin concentration, 30% to 90% is Hb F.
• BM: hyperplasia is seen in bone XR.
• Iron study: elevated S. ferritin & transferrin saturation.
Treatment:
• The mainstay of treatment is transfusion with packed RBCs using irradiated CMV –ve blood, a post transfusion Hb level of 10 gm/dl is the goal.• In an effort to prevent hemochromatosis, patients who receive chronic transfusion regimens are treated with chelating agents (e.g.deferoxamine, deferasirox) that promote iron removal from the body through excretion in the urine and the stool.
• Splenectomy is usually considered when transfusion requirements exceed 250 ml /kg/year.
• Stem cell transplantation can cure the patients.
• Genetic counseling.